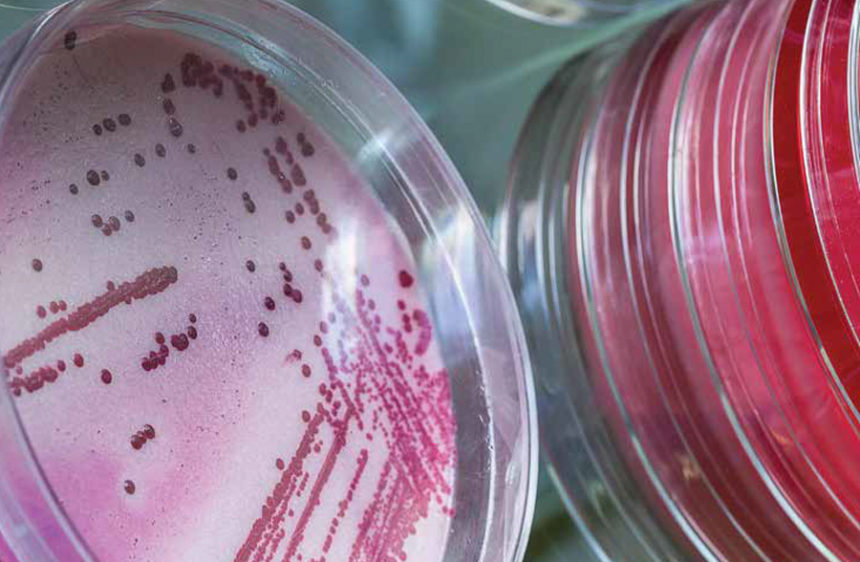
Harnessing AI to Catch Disease Fast

Up to 27,000 microbiology laboratories around the world could benefit from a ground-breaking automation technology…
Month: August 2017
Scientists at the National Institutes of Health have expanded the understanding of how chronic inflammation…
Given the possible security vulnerabilities related to developments in synthetic biology – a field…
Biological “detectives” are tracking down biothreats such as the bacteria that causes tularemia (“rabbit fever”),…
National Institutes of Health scientists have filled a research gap by developing a laboratory model…
A protein called COUP-TFII determines whether a mouse embryo develops a male reproductive tract, according…
Hospital-acquired pneumonia (HAP) is a neglected disease among the health care-associated infections. HAP is…
A new study from Harvard has found greater risk of breast cancer in women who…
If CO2 levels continue to rise as projected, the populations of eighteen countries may lose more…
Researchers from the National Institutes of Health have identified a class of sensory neurons (nerve…